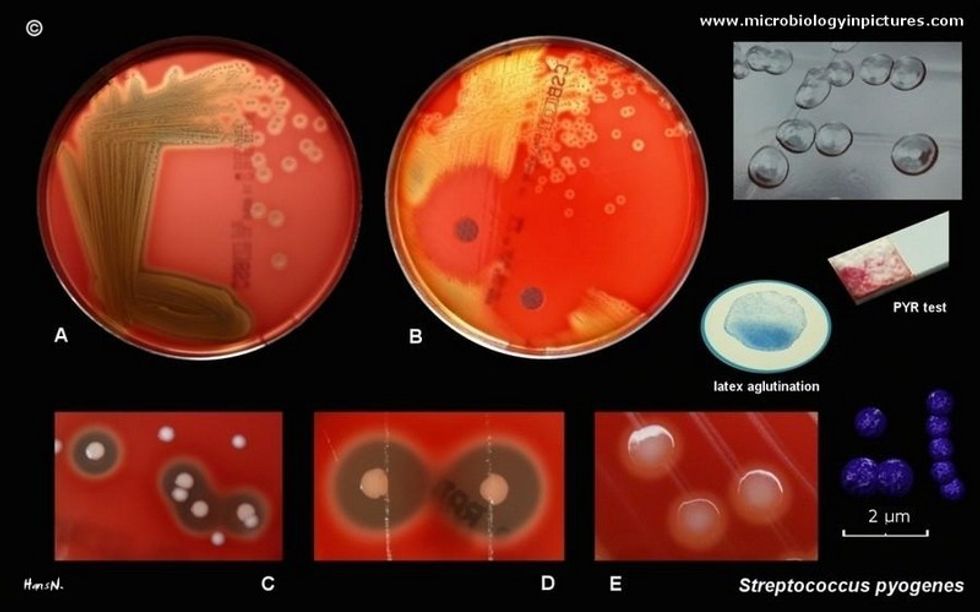
streptococcus pyogenes

Infeksionet e fytit – shkaktar Streptococcus pyogenes - gr. A

Infeksionet streptokoksike të grupit A, shkaktojnë: faringjitin streptokoksik, skarlatinë, piodermi streptokoksike, erizipel, ethet e lehonisë e deri të sepsa dhe sëmundjet poststreptokoksike. Mostrajtimi adekuat dhe në kohë i infeksionit, bart pasoja serioze në organizëm. Dr. Afërdita Kuqi – Hyseni Specialiste e Mikrobiologjisë klinike Spitali Amerikan, Kosovë Rr. "Shkupi", nr.25, Prishtinë +381 38 221 661 +377 49 933 868 aferdita.kuqi@spitaliamerikan.com www.spitaliamerikan.com
- Me fillimin e ditëve ftohta edhe infeksionet e fytit dhe të rrugëve të sipërme respiratore janë më të shpeshta si pasojë e qëndrimit në ambiente të mbyllura dhe bartja e infeksionit nga një person tek tjetri bëhet përmes rrugëve sperklo-ajrore.
- Bajamet janë një portë mbrojtëse e Traktit të sipërm respirator. Në këtë regjion ekziston numër i madh i baktereve të cilat janë florë normale dhe mbrojtëse për organizmin tonë.
Bakteret e tilla që ndodhen si florë normale janë Streptococcus viridians dhe ato jo-hemolitike, që janë të afta të prodhojnë disa substanca të quajtura Bakteriocina, të cilat frenojnë rritjen e baktereve patogjene.
1. Toksinat eritrogjene të prodhuara janë përgjegjëse për ekzantemën gjatë Skarlatinës.
2. Toksinat Streptolizina S dhe O, Streptolizina S është e qëndrueshme ndaj O2, nuk është imunogjene dhe tretë eritrocitet, leukocitet dhe trombocitet. Kjo toksinë nxitë çlirimin e lizozimave që dëmtojnë fagocitet.
- Streptolizina O - kundër kësaj toksine formohen antitrupa-Antistreptolizina O, përcaktimi i të cilave është i dobishëm për të dokumentuar një infeksion recent streptokoksik (analiza ASO).
3. Streptolizina A dhe B janë enzime të afta për të tretur koagulat e gjakut dhe mundësojnë përhapjen e shpejtë të Streptokokeve jashtë kufijve të zonës inflamatore.
4. ADN-azat janë enzime citolitike ku duke pakësuar viskozitetin e qelbit në absceset ato lehtësojnë përhapjen e Streptokokut.
5. Hijaluronidaza enzime, gjithashtu ndihmon në përhapjen e baktereve.
Shkaktarët e Tonsillofaringitit Tonsillofaringitin në 90% të rasteve e shkaktojnë viruset si: Adenoviruset, Coxsackie Viruset ,Epstein barr viruset etj. Vetëm në 10% të rasteve shkaktar është Streptococcus pyogenes, grupi A, potencohet kjo baktere agresive për shkak të lirimit të shumë toksinave.

Dhimbja e fytit është simptoma më e shpeshtë e infeksionit që përcillet me gëlltitje të vështirësuar, skuqje fyti, tharje fyti, kollë, dhimbje muskujve, dhimbje barku dhe temperaturë. Hapi i parë që duhet ndërmarrë është bërja e një Strisho fyti, ku si rregull është që pacienti duhet të jetë esëll dhe nuk duhet të jetë nën ndikimin e antibiotikeve, sepse kjo frenon rritjen e baktereve dhe nuk do të kemi rezultat real.
- Strep-Test është një test i shpejtë dhe orientues që në rast të prezencës së Streptococcus pyogenes, grupi A, detekton pozitivitetin dhe përfitojmë në kohë që të fillohet sa më parë me antibiotik.
- Farigjiti streptokoksik është sëmundje kryesore e moshës së fëmijërisë 5-15 vjeç, ndonëse dhe moshat e tjera mund të prekën.
- Përhapja e infeksionit bëhet me rrugë sperklo-ajrore ndërmjet individëve, pikërisht kjo është arsyeja pse kemi raste më të shpeshta gjatë ditëve të ftohta, sepse kemi kontakte më të shpeshta dhe më të afërta në ambientet e mbyllura.
Rëndësia e madhe e izolimit të Streptococcus pyogenes, grupi A nga Kultura e grykës për trajtimin me kohë është mjaftë efektive para se bakteri të krijojë sekuela dhe antitrupa Antistreptolizine. Prania e Antitrupave Streptolizine O mund të detektohen 3-4 javë pas infeksionit me Testin ASO (ky test tregon nivelin e antitrupave kundër toksinës Streptolizin O).
Infeksionet streptokoksike të grupit A, shkaktojnë: faringjitin streptokoksik, skarlatinë, piodermi streptokoksike, erizipel, ethet e lehonisë e deri të sepsa dhe sëmundjet poststreptokoksike. Mostrajtimi adekuat dhe në kohë i infeksionit, bart pasoja serioze në organizëm siç, janë me vonë shfaqja e etheve reumatike, endokardit dhe glomerulonefrit.
Mjekimi me kohë ndaj infeksionit streptokoksik nuk ka për qëllim vetëm mënjanimin e simptomave klinike, por të parandalojë ndërlikimet e mëvonshme që lënë gjurmë kjo baktere, siç janë ndërlikimet supurative: otitis, mastoiditis, sinuzitis etj., dhe ato jo supurative: ethet reumatizmale, glomerulonefritin dhe endokarditin.
/Telegrafi/